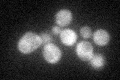
YGL178W
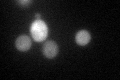
YGL178W

View description
Member of the Puf family of RNA-binding proteins; binds to mRNAs encoding chromatin modifiers and spindle pole body components; involved in longevity, maintenance of cell wall integrity, and sensitivity to and recovery from pheromone arrest
Localization:
Intensity:
Fold change:
Significance:
-
C’ GFP library in SD
cytosol37.45 -
N' NOP1pr-GFP in SD

N/A0 -
N' TEF2pr-mCherry in SD

N/A0 -
N' NATIVEpr-GFP in SD

N/A0 -
N' TEF2pr-VC and Cyto-VN in SD

N/A0 -
C’ GFP library in SD+DTT
cytosol59.241.58Yes -
C’ GFP library in SD+H2O2

cytosol44.691.19No -
C’ GFP library in Starvation Media

cytosol33.60.89No -
C’ GFP library on the background of Pup2-DaMP

cytosol -
C’ GFP library on the background of CCT mutant

cytosol42.15981.12566No
